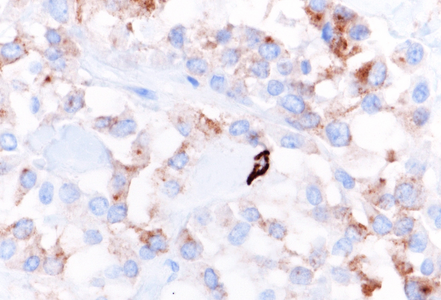

-
Die Universität
- Herzlich willkommen
- Das sind wir
- Medien & PR
-
Studium
- Allgemein
- Studienangebot
- Campusleben
-
Forschung
- Profil
- Infrastruktur
- Kooperationen
- Services
-
Karriere
- Arbeitgeberin Med Uni Graz
- Potenziale
- Arbeitsumfeld
- Offene Stellen
-
Diagnostik
- Patient*innen
- Zuweiser*innen
- Gesundheitsthemen
- Gesundheitsinfrastruktur
Case of the Month
May 2025
Pancreatic tumor in a 52-year-old female.
Diagnosis
Solid pseudopapillary neoplasm (SPN) of the pancreas.
Comment
A distal (caudal) pancreatectomy was performed on a 52-year-old female who presented with a macroscopically cystic pancreatic tumor containing firm and solid areas, measuring 6 cm in greatest dimension.
Histological examination revealed a well-circumscribed neoplasm with a fibrous capsule (Panel A), composed of uniform, poorly cohesive cells arranged in both solid (Panel B) and pseudopapillary structures (Panel C). The pseudopapillae resulted from degenerative changes leading to detachment of tumor cells from another and from central fibrovascular cores. Stromal hyalinization was also noted (Panel D). The neoplastic cells were monomorphic, with round to oval nuclei showing finely dispersed chromatin, inconspicuous nucleoli, and moderate amounts of eosinophilic to clear cytoplasm. Mitoses were not seen.
Immunohistochemically, the tumor cells showed diffuse and strong nuclear and cytoplasmic positivity for β-catenin (Panel E). They also expressed CD56/NCAM (Panel F), progesterone receptor (Panel G), CD10, and cyclin D1, with focal positivity for synaptophysin (Panel H). The tumor cells were negative for cytokeratins, chromogranin, and trypsin, and loss of membranous E-cadherin expression was observed. The Ki-67 proliferation index was low (<5%).
Solid pseudopapillary neoplasm (SPN) of the pancreas is a rare epithelial tumor, characterized by low malignant potential and lacking a specific line of differentiation. Initially described by Virginia Frantz in 1959 and later incorporated into the WHO classification in 1996, SPN accounts for approximately for 1–2.7% of all exocrine pancreatic neoplasms and only 5% of cystic neoplasms.
It most commonly affects young women in the second to fourth decades of life and typically presents as a solitary, well-circumscribed mass located in the pancreatic body or tail.
The marked predilected distribution has raised the hypothesis of hormonal involvement in tumor development; however, no definitive association has been established so far. Interestingly, morphologically identical neoplasms have also been reported in the ovary and testis, suggesting that the progenitor cells of SPNs may originate in the genital ridges and become displaced to the pancreas during embryonic development.
This entity is characterized by a heterogeneous appearance, including various proportions of solid and pseudopapillary components, often accompanied by hemorrhage, pseudocystic changes, foamy macrophages and cholesterol crystals deposits.
Neoplastic cells are poorly cohesive and show characteristic features including moderate eosinophilic cytoplasm, intracytoplasmic PAS-positive, diastase-resistant hyaline globules, and nuclei with longitudinal grooves and finely textured chromatin. In addition to these, some variants have been described, including oncocytic, pigmented, and clear cells subtypes. Despite their typically indolent behavior, rare aggressive cases demonstrate high mitotic activity, necrosis, and sarcomatoid features.
Most tumors harbor somatic mutations in the CTNNB1 gene, which encodes beta-catenin gene, thus resulting in its nuclear accumulation and nuclear/cytoplasmic immunoreactivity. This mutation disrupts beta-catenin’s role in cell-cell adhesion at the membrane level, most likely contributing to the characteristic cellular discohesion observed and explaining the loss of membranous E-cadherin expression.
Currently classified as a low-grade malignant neoplasm, the prognosis is overall excellent, with a curative rate of > 95% following complete surgical resection. Despite occasional local recurrence or metastasis, long-term outcomes remain favorable and significantly better compared to other pancreatic tumors.
For further reading
- La Rosa S, Bongiovanni M. Pancreatic solid pseudopapillary neoplasm: key pathologic and genetic features. Arch Pathol Lab Med. 2020; 144: 829–837.
- Abudalou M, Vega EA, Dhingra R, Holzwanger E, Krishnan S, Kondratiev S, Niakosari A, Conrad C, Stallwood CG. Solid pseudopapillary neoplasm–diagnostic approach and post-surgical follow-up: three case reports and review of literature. World J Clin Cases. 2021; 9: 1682–95.
- Lu X, Chen H, Zhang T. Solid pseudopapillary neoplasm (SPN) of the pancreas: current understanding on its malignant potential and management. Discov Oncol. 2024; 15: 77.
- Omiyale AO. Solid pseudopapillary neoplasm of the pancreas. World J Hepatol. 2021 Aug 27; 13: 896–903.
Presented by
Dr. Julia Azevedo, Porto, Portugal, and Dr. Cord Langner, Graz, Austria.